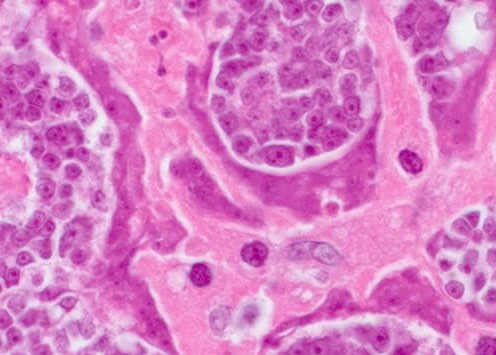

La halitosis se debe a los parásitos.
Un especialista en enfermedades infecciosas explica cómo salvarse a sí mismo y a sus seres queridos
De los editores: Los médicos han descubierto una nueva causa de la halitosis (mal aliento): la infección parasitaria. Un estudio realizado recientemente informa de que los productos de desecho de los parásitos son tóxicos y forman un entorno favorable en el tracto digestivo para el desarrollo de bacterias putrefactas. Por ello, las personas infectadas por parásitos pueden sufrir un mal aliento persistente.

Dr. Alfonso López Soto: Doctor en Ciencias Médicas, catedrático, director del Instituto de Parasitología de España y presidente del Centro de Investigación Parasitológica, miembro del Consejo de la Asociación Europea de Parasitología, autor de 5 libros sobre parásitos y sus métodos de tratamiento. Experiencia académica - 26 años
Hoy hablamos de ello con el presidente del Instituto de Parasitología de España Dr. Alfonso López Soto.
Corresponsal: ¡Buenas tardes, Alfonso! Empecemos por la pregunta principal, ¿es cierto que España es líder en infectar a la población con parásitos?
Sí. España ocupa un lugar destacado en el ranking de infestaciones de plagas. Las principales causas son: el mal ambiente, la inercia de las autoridades y su desprecio por los ciudadanos.
Corresponsal: ¿Hasta qué punto son ciertos los datos de la investigación sobre la relación entre la infestación parasitaria y la halitosis?
Dr. Alfonso López Soto: Hasta hace un par de años, la comunidad médica creía que la halitosis estaba asociada a la colonización de bacterias en la cavidad bucal, lo cual es parcialmente cierto. Sin embargo, estudios recientes han demostrado que otra causa importante son los problemas en el estómago y el esófago (que siempre están infectados por parásitos). Los científicos concluyeron que sería imposible ignorar un "síntoma tan común". La infección parasitaria provoca casi todas las enfermedades graves en el ser humano.

La halitosis es un signo claro de la presencia de parásitos en el organismo, que corren el riesgo de causar complicaciones mortales.
Personalmente, confío en la investigación y puedo decir que está confirmada por los estudios realizados en nuestra institución. Así, la halitosis trivial puede convertirse en una enfermedad grave. En general, cerca del 92% de las muertes humanas son causadas por infecciones parasitarias. Y no se trata sólo de la muerte por enfermedad. La gran mayoría de las llamadas "muertes naturales" son consecuencia de la actividad de los parásitos en el organismo.
Corresponsal: Corresponsal: ¿La gente suele entender que los parásitos, los gusanos triviales, provocan halitosis?
Dr. Alfonso López Soto: Efectivamente, es una gran ilusión, creer que los parásitos humanos son exclusivamente gusanos. Hay un gran número de parásitos que viven en diferentes órganos, con consecuencias muy diferentes entre ellos, los gusanos y para ser más precisos, los helmintos son muy peligrosos, literalmente, destruyen el intestino, llevando a la descomposición y por lo tanto a la muerte. Además, los helmintos son muy difíciles de encontrar incluso con pruebas especializadas y de erradicar con terapias específicas.
A menudo, junto a ellos hay miles de otros parásitos que pueden vivir en el hígado, el cerebro, los pulmones, la sangre y el estómago. Casi todas son mortales, algunas comienzan a actuar inmediatamente de forma agresiva y destruyen el organismo, otras actúan de forma imperceptible hasta que su número es tal que el organismo anfitrión ya no puede resistirlas y la persona muere.
Con esto, puedo decir con seguridad que casi todos ellos están infectados con parásitos. La mayoría de las especies de parásitos son extremadamente difíciles de diagnosticar; cuando aparecen los síntomas de la infestación parasitaria, los médicos intentan tratarlos, pero se necesitan pruebas específicas para detectar las distintas especies de parásitos, lo que hace muy difícil prescribir un tratamiento específico.
Corresponsal: ¿Puede dar ejemplos concretos de infestación de plagas?
Dr. Alfonso López Soto: Puedo contar cientos de casos, en aras de la claridad sólo hablaré de los casos en los que el peligro de los parásitos es indiscutible.
En primer lugar, como resulta que algunas tenias son capaces de provocar cáncer, no es la propia persona la que está formalmente infectada, sino los gusanos, sus células malignas difundidas por ellos por todo el cuerpo, infectando todo el organismo. Esto ocurre cuando las larvas del gusano pasan del intestino a los ganglios linfáticos de la persona.
Como resultado, se convierten en tumores cancerosos, infectando rápidamente a los humanos. La muerte se produce en pocos meses. Esta semana se ha registrado otro caso de muerte de una persona por enfermedades similares. En el centro de esta foto: células de un tumor maligno transmitido a un humano por un gusano parásito.
Los parásitos contribuyen a los tumores cancerosos
Otra enfermedad muy extendida es la infección parasitaria en el cerebro humano. Esto conduce a la neurosis, el agotamiento rápido, la excitación excesiva, los cambios de humor repentinos y, en casos de infestaciones generalizadas, a la muerte.

Los parásitos provocan hemorragias cerebrales

El tumor cerebral causado por parásitos sólo se puede diagnosticar en dos clínicas de España
El tercer ejemplo es la infestación parasitaria del corazón. Se cree que es una enfermedad moderadamente común. Pero en realidad, alrededor del 23% de las personas tienen filaria. Casi uno de cada cuarto está afectado.
En la fase inicial, son completamente invisibles, su efecto en el cuerpo se reduce a cero. Pero cuanto más tiempo pasa, más evidente es la actividad de los gusanos en el corazón. Son la principal causa de muchas enfermedades del corazón, y si hablamos de la muerte súbita por insuficiencia cardíaca, entonces por la cuota de estos parásitos, casi el 100% se produce en estos casos.

En 2 meses, los parásitos destruyeron el corazón de un milanés de 45 años

Las larvas del parásito se propagan por el cuerpo con la sangre
Corresponsal: ¿Qué otros problemas pueden atribuirse a las infecciones parasitarias?
Dr. Alfonso López Soto: Los parásitos causan prostatitis, impotencia, adenoma, cistitis, cálculos renales y vesicales en los hombres.
En las mujeres: dolor e inflamación de los ovarios, desarrollo de fibromas, miomas, mastopatía fibroquística, inflamación de las glándulas suprarrenales, de la vejiga y de los riñones y, por supuesto, envejecimiento prematuro de la piel.
Corresponsal: ¿Cómo protegerse de las plagas? ¿Existen pruebas y productos plaguicidas?
Dr. Alfonso López Soto: Desgraciadamente, se puede decir que hoy en día no existen herramientas realmente precisas para diagnosticar los parásitos dentro de una persona. Esto se debe en parte a la presencia de un gran número de especies de parásitos (miles de variantes) y en parte al altísimo nivel de complejidad de los equipos necesarios para el diagnóstico. El procedimiento para un análisis completo de parásitos en España está disponible en pocas clínicas y cuesta mucho dinero
Los primeros síntomas por los que se puede saber que los parásitos viven en el cuerpo de un paciente son:
- 1. Mal aliento.
- 2. Sudoración excesiva.
- 3. Alergias (erupciones, lagrimeo, mareos).
- 4. Enfermedades frecuentes, amigdalitis, congestión nasal.
- 5. Fatiga crónica (te cansas rápidamente, hagas lo que hagas).
- 6. Dolores de cabeza frecuentes, estreñimiento o diarrea.
- 7. Dolor articular y muscular.
- 8. Dolor en el abdomen, disminución del apetito.
- 9. Nerviosismo, trastornos del sueño e insomnio.
- 10. Ojeras, bolsas bajo los ojos.
En presencia de al menos dos de estos síntomas, hay un 99% de probabilidades de que tenga parásitos en su cuerpo.
Si se trata de productos farmacéuticos, la cuestión es muy problemática. Hoy en día sólo existe un compuesto que permite deshacerse de los parásitos, por cierto, fue creado en suelo español por nuestros científicos.
Corresponsal: ¿Qué es este producto? ¿Quién lo creó? ¿Puede decirme algo más?
Dr. Alfonso López Soto: El antiparasitario Nemanex fue creado con la participación de nuestro Instituto de Parasitología y un grupo de científicos europeos independientes. Estábamos trabajando en dos docenas de remedios contra las plagas al mismo tiempo. Pero en el transcurso del estudio, se decidió centrar la investigación en el desarrollo de Nemanex como la opción más eficaz.
El instrumento es un compuesto fisiológicamente activo de alta calidad, con extractos de plantas altamente concentrados. El spray está compuesto por extracto de semilla de calabaza, extracto de tomillo, extracto de hoja de nogal, muchos otros extractos naturales, así como vitaminas y minerales. Las gotas se componen de extracto de semilla de calabaza, extracto de tubérculo de alcachofa de Jerusalén, extracto de hoja de nogal, extracto de hoja de alcachofa y otros extractos, así como de vitaminas. En el proceso de creación y prueba, esta herramienta demostró ser extremadamente eficaz; si sólo se tratara de dinero, todo el volumen de producción se enviaría a la exportación. En toda Europa, están dispuestos a comprar Nemanex prácticamente a cualquier precio. Pero tenemos una petición del Ministerio de Sanidad español para que una cantidad importante del producto se quede en el país y se venda principalmente a los ciudadanos españoles.
El margen de exportación para los compradores europeos de Nemanex es diez veces superior a su coste, lo que nos permite comercializarlo en España a precios muy inferiores al coste.
Corresponsal: ¿Por qué es tan bueno Nemanex? ¿En qué se diferencia de otras opciones para erradicar los parásitos del organismo?
Dr. Alfonso López Soto: Como ya he dicho, hasta la fecha es el único medio de limpieza de parásitos que existe en el mundo. Por ello, las cadenas y empresas farmacéuticas internacionales la persiguen. En comparación con otros fármacos antiparasitarios, este remedio actúa inmediatamente contra todo el espectro de parásitos de los que pueden estar infectadas las personas.
En lo que respecta a los problemas de diagnóstico, Nemanex le permite limpiar de forma eficaz y segura todo su cuerpo sin coste adicional. Ya he mencionado que es prácticamente imposible saber con qué tipo de parásitos está infectada una persona. Un Nemanex elimina y remueve los parásitos que viven en todas partes, desde el cerebro y el corazón hasta el hígado y los intestinos. Esta capacidad es única; ninguno de los fármacos existentes en la actualidad consigue tener un efecto tan amplio.
El preparado está disponible en forma de gotas para obtener el mejor resultado. El spray funciona muy bien con él: mejora la acción y ambos productos funcionan juntos de manera segura, efectiva y rápida.

No se trata de un medicamento químico, sino de un producto completamente natural que, por lo tanto, no puede desencadenar reacciones alérgicas, desequilibrios intestinales y otros problemas que pueden producirse durante el tratamiento con píldoras clásicas.
Corresponsal: Creo que nuestros lectores estarán interesados en saber dónde comprar Nemanex.
Dr. Alfonso López Soto: En este punto, cabe destacar que Nemanex sólo está disponible bajo pedido en la web del fabricante. Hemos intentado muchas veces ponernos en contacto con las cadenas de farmacias, pero quieren subir el precio y hacerlo mucho más caro de lo que nos gustaría. Nuestro Instituto de Parasitología es un centro no comercial. Nuestro objetivo no es ganar dinero. Sólo queremos proporcionar a toda la población esta herramienta. Por lo tanto, lo vendemos con pérdidas, recuperando la diferencia a costa de su exportación. Y el principal objetivo de las cadenas de farmacias es ganar dinero. Por lo tanto, tenemos enfoques radicalmente diferentes de la fijación de precios.
Espero que con el tiempo podamos llegar a un acuerdo y que Nemanex esté disponible en las farmacias al mismo precio. Mientras que ahora sólo se puede pedir por internet. Hemos intentado que todo sea cómodo y sencillo: el instrumento se entrega por correo o mensajería y el pago sólo se realiza tras su recepción y verificación.
Corresponsal: ¿Quizás quiera decir algo a nuestros lectores antes de que terminemos la entrevista?
Dr. Alfonso López Soto: Lo único que quiero decir es que cuiden su vida y su salud. Puede que no lo sospeche, pero en su interior, con una probabilidad del 97-98%, viven parásitos. Pueden estar en cualquier parte: en la sangre, los intestinos, los pulmones, el corazón, el cerebro. Los parásitos te devoran literalmente desde dentro, envenenando al mismo tiempo tu organismo. Como resultado, aparecen muchos problemas de salud que acortan la vida entre 15 y 25 años. Esto se debe al problema de las muertes súbitas, que suelen estar asociadas a la influencia de los parásitos en el cuerpo humano, cuyo primer síntoma evidente es la halitosis.

¡Importante! Se llegó a la conclusión de que es el mejor momento para empezar a tratar los parásitos en el cuerpo. Debido a la disminución de la temperatura media, el intercambio de sustancias y la circulación sanguínea en las células se reducen, el efecto del uso de Nemanex aumenta. La eliminación de los parásitos del cuerpo es un 47% más rápida que con el frío.
Aparecido en España hace menos de un año, el antiparasitario Nemanex ha provocado una auténtica revolución en el control de plagas y la prevención de muchas enfermedades graves y a menudo letales.
En relación con esto, el aumento de la demanda de este producto ha provocado la aparición en el mercado de productos chinos baratos y no certificados. Visualmente o al tacto es difícil reconocer una falsificación, especialmente cuando no se sabe cómo debería ser el pesticida original.
Por lo tanto, tenga cuidado al comprar el agente plaguicida Nemanex: ¡ no lo compre nunca a vendedores no especializados, o cuando el producto carezca de certificado!

P.D.: Hemos pedido al Dr. Alfonso López Soto un descuento adicional para nuestros lectores. Vino a visitarnos y ahora todo el mundo puede beneficiarse de Nemanex con un descuento adicional.

